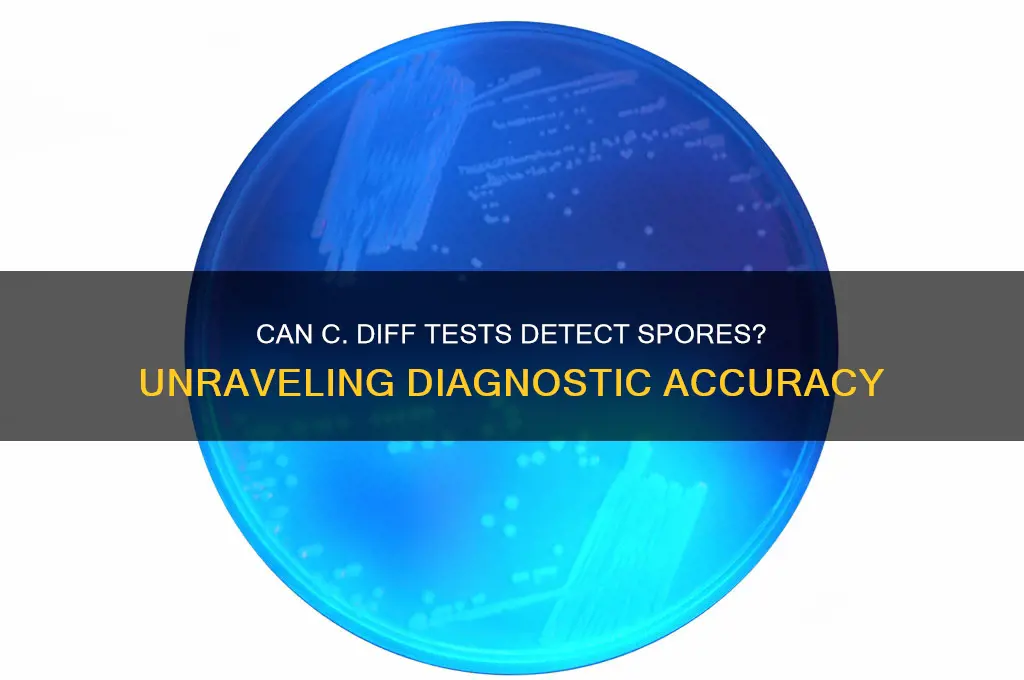
can a c diff test detect spores

The question of whether a *C. diff* test can detect spores is a critical one, as *Clostridioides difficile* (formerly *Clostridium difficile*) is known to produce highly resilient spores that contribute to its persistence and transmission. Standard *C. diff* diagnostic tests, such as toxin assays, PCR, and GDH antigen tests, are primarily designed to detect the presence of the bacterium, its toxins, or specific genetic material, rather than spores directly. While these tests can identify active infection, they do not specifically target or confirm the presence of spores. Detecting spores typically requires specialized techniques, such as spore-specific PCR or culture methods, which are not routinely used in clinical settings. Understanding this distinction is essential, as spores play a significant role in *C. diff* recurrence and environmental contamination, highlighting the need for comprehensive strategies to address both active infection and spore-related risks.
| Characteristics | Values |
|---|---|
| Detection of Spores | Most standard C. diff tests (e.g., toxin A/B assays, GDH) do not directly detect spores; they detect toxins or the presence of the bacteria. |
| Spore-Specific Tests | Specialized molecular tests (e.g., PCR) can detect C. diff DNA, which may indicate the presence of spores, but they do not differentiate between spores and vegetative cells. |
| Spore Viability | Standard tests cannot determine if spores are viable or capable of causing infection. |
| Clinical Relevance | Spores are the infectious form of C. diff, but their detection is not routinely required for diagnosis. |
| Testing Methods | Toxin assays, GDH tests, PCR, and culture methods are commonly used, but none specifically target spores. |
| Limitations | Current tests focus on active infection (toxin production or bacterial presence) rather than spore detection. |
| Research Advances | Emerging techniques (e.g., spore-specific PCR or spore staining) are being explored but are not yet standard clinical practice. |
| Importance of Spores | Spores are critical for transmission and recurrence, but their detection is not necessary for initial diagnosis or treatment. |
Explore related products
$52.79 $69.99
$177.64
What You'll Learn
- Test Sensitivity Limits: Most tests detect toxins or DNA, not spores directly due to lower sensitivity
- Spore Detection Methods: Specialized tests like PCR or culture may indirectly indicate spore presence
- Toxin vs. Spores: Standard tests detect toxins, not spores, which can lead to false negatives
- Culture Techniques: Anaerobic cultures can grow spores but are time-consuming and not routine
- PCR Specificity: PCR can detect *C. diff* DNA, but not differentiate between spores and vegetative cells

Test Sensitivity Limits: Most tests detect toxins or DNA, not spores directly due to lower sensitivity
Clostridioides difficile (C. diff) testing primarily targets toxins or bacterial DNA, not spores, due to the inherent limitations in sensitivity of current diagnostic methods. Toxin-based assays, such as enzyme immunoassays (EIAs), detect toxins A and B, which are produced by active C. diff bacteria. While these tests are widely used, they rely on the presence of sufficient toxin levels, which may not always correlate with spore presence or disease severity. DNA-based tests, like polymerase chain reaction (PCR), identify C. diff genetic material but cannot distinguish between viable vegetative cells and dormant spores. This distinction is critical because spores are the primary mode of transmission and environmental persistence, yet they remain undetected by these conventional methods.
The challenge lies in the analytical sensitivity required to detect spores directly. Spores are metabolically inactive and lack the toxin production or DNA amplification characteristics that make vegetative cells detectable. Current tests are optimized for clinical diagnosis, focusing on active infection rather than spore carriage. For instance, PCR assays can detect as few as 10–100 genome copies per reaction, but this sensitivity does not extend to the unique biochemical signatures of spores. Direct spore detection would require specialized techniques, such as spore-specific PCR primers or culture-based methods, which are not yet standardized for routine clinical use.
From a practical standpoint, this limitation has significant implications for infection control and patient management. Healthcare facilities often rely on toxin or DNA detection to identify active C. diff infections, but these tests fail to address the environmental reservoir of spores. Patients may test negative for toxins or DNA despite carrying spores, which can later germinate and cause recurrent infections. For example, a study in *Clinical Microbiology Reviews* highlighted that up to 50% of patients with recurrent C. diff infections had undetectable toxin levels but persisted as spore carriers. This underscores the need for complementary strategies, such as environmental decontamination with sporicidal agents like chlorine dioxide or hydrogen peroxide vapor, to target spores directly.
To bridge this diagnostic gap, emerging technologies are being explored. Spore-specific assays, such as those targeting spore coat proteins or germination markers, show promise but remain in developmental stages. Until these methods become clinically available, healthcare providers must interpret test results with caution, recognizing that a negative result does not rule out spore carriage. For high-risk populations, such as elderly patients or those with prolonged antibiotic exposure, empirical measures like contact precautions and enhanced cleaning protocols should be implemented, even in the absence of direct spore detection.
In conclusion, the inability of current C. diff tests to detect spores directly stems from their design focus on toxins or DNA, which are markers of active infection rather than dormant spore presence. This limitation necessitates a multifaceted approach to C. diff management, combining diagnostic testing with environmental and epidemiological strategies. As research advances, the development of spore-specific assays will be crucial for improving infection control and reducing the burden of C. diff-associated disease. Until then, clinicians and infection prevention teams must remain vigilant, treating the unseen spore reservoir as a silent but significant threat.
Are Mold Spores Carcinogens? Uncovering the Health Risks and Facts
You may want to see also

Spore Detection Methods: Specialized tests like PCR or culture may indirectly indicate spore presence
Clostridioides difficile (C. diff) spores are a resilient, dormant form of the bacterium, capable of surviving harsh conditions and contributing to recurrent infections. While standard C. diff tests primarily detect toxins or the bacterium itself, identifying spores requires specialized methods. Polymerase chain reaction (PCR) and culture techniques, though not direct spore detectors, can provide indirect evidence of spore presence by amplifying genetic material or cultivating the organism under specific conditions.
PCR, a molecular technique, amplifies DNA sequences specific to C. diff, including those associated with spore formation. For instance, detecting genes like *tcdA*, *tcdB*, or *cdt* can suggest the presence of toxigenic strains, which are more likely to produce spores. However, PCR alone cannot differentiate between vegetative cells and spores. To enhance specificity, some protocols incorporate spore-specific markers or combine PCR with spore enrichment steps, such as heat treatment (e.g., 80°C for 10 minutes) to kill vegetative cells before testing. This approach increases the likelihood that detected DNA originates from spores.
Culture methods, on the other hand, involve growing C. diff in a controlled environment. Spores can be selectively cultured by using ethanol treatment (e.g., 95% ethanol for 1 hour) to kill vegetative cells, allowing only spores to germinate and form colonies. While this method is more labor-intensive and time-consuming (requiring up to 48–72 hours), it provides a definitive indication of spore viability. Combining culture with toxin or PCR testing can further confirm the presence of toxigenic spores, offering a comprehensive assessment of infection risk.
A practical tip for clinicians: when recurrent C. diff infections are suspected, request PCR or culture tests with spore-specific protocols. For example, specify "PCR with heat treatment" or "ethanol-treated culture" to target spores. This ensures a more accurate evaluation of the patient’s spore burden, guiding treatment decisions, such as extended antibiotic courses or fecal microbiota transplantation.
In summary, while no test directly detects C. diff spores, PCR and culture methods can indirectly indicate their presence through targeted protocols. These techniques, when applied with spore-specific modifications, provide valuable insights into the role of spores in infection persistence and recurrence, making them essential tools in clinical and research settings.
Do Fungi Produce Spores Above Ground? Exploring Fungal Reproduction
You may want to see also

Toxin vs. Spores: Standard tests detect toxins, not spores, which can lead to false negatives
Standard diagnostic tests for *Clostridioides difficile* (C. diff) primarily target toxins produced by the bacteria, not the spores themselves. This distinction is critical because spores are the dormant, resilient form of C. diff that can survive harsh conditions, including antibiotics and environmental stressors. While toxin detection is essential for identifying active infection, it overlooks the presence of spores, which can persist in the gut and environment, posing a risk for recurrence or transmission. This limitation underscores why standard tests may yield false negatives, particularly in cases where spores are present but toxin production is minimal or intermittent.
Consider a patient who has recently completed a course of broad-spectrum antibiotics. Despite harboring C. diff spores in their gut, toxin levels may be undetectable, leading to a false negative result. This scenario is especially problematic in healthcare settings, where asymptomatic carriers with spore-positive stools can unknowingly spread the infection. For instance, a study published in the *Journal of Clinical Microbiology* found that up to 20% of patients with recurrent C. diff infections had spore-positive stools despite negative toxin tests. This highlights the need for more comprehensive testing strategies that account for both toxins and spores.
From a practical standpoint, clinicians must interpret negative toxin test results with caution, particularly in patients with a history of C. diff or recent antibiotic use. In such cases, additional diagnostic tools, such as nucleic acid amplification tests (NAATs) or spore detection assays, may be warranted. NAATs, while highly sensitive for detecting C. diff DNA, still do not differentiate between spores and vegetative cells. Emerging spore-specific tests, such as those using spore-coat protein markers, offer promise but are not yet widely available. Until these technologies become standard, clinicians should rely on clinical judgment and patient history to guide treatment decisions.
The implications of this toxin-spore detection gap extend beyond individual patient care to public health. In long-term care facilities, where C. diff outbreaks are common, failing to detect spores can perpetuate transmission cycles. Environmental disinfection protocols, such as using spore-specific disinfectants like bleach (1:10 dilution of household bleach), are essential but often overlooked. Similarly, hand hygiene with soap and water is more effective than alcohol-based sanitizers for removing spores, a critical detail for healthcare workers managing C. diff patients.
In conclusion, the reliance on toxin detection in standard C. diff tests creates a blind spot for spores, which are key players in infection persistence and transmission. While toxin tests remain the cornerstone of diagnosis, their limitations necessitate a multifaceted approach. Clinicians should remain vigilant for false negatives, especially in high-risk populations, and advocate for the development and adoption of spore-detecting technologies. Until then, combining clinical acumen with stringent infection control measures is the best defense against this resilient pathogen.
Understanding Spores: The Silent Killers in The Last of Us
You may want to see also
Explore related products
$12.59 $15.9

Culture Techniques: Anaerobic cultures can grow spores but are time-consuming and not routine
Anaerobic culture techniques stand out as one of the few methods capable of detecting *Clostridioides difficile* spores, but their utility is tempered by significant practical limitations. Unlike rapid antigen or molecular tests, which target toxin or DNA but may overlook spores, anaerobic cultures provide a more comprehensive assessment by allowing spores to germinate and grow under controlled conditions. This makes them invaluable in research or complex clinical scenarios where understanding spore viability is critical. However, the process requires specialized equipment, such as anaerobic chambers or gas-generating pouches, to mimic the oxygen-free environment *C. difficile* thrives in. Without these, spores remain dormant, rendering the test ineffective.
The time-consuming nature of anaerobic cultures is their most glaring drawback. While toxin-based tests yield results within hours and PCR assays within a day, anaerobic cultures demand 48 to 72 hours—or longer—to confirm growth. This delay is due to the slow germination and replication of *C. difficile* spores, which must first activate under favorable conditions before colonies become visible. For instance, a study in *Journal of Clinical Microbiology* noted that spore detection via culture took up to 96 hours in some cases, compared to 24 hours for PCR-based methods. Such timelines make anaerobic cultures impractical for routine diagnostics, where rapid results guide immediate treatment decisions.
Despite their limitations, anaerobic cultures remain essential in specific contexts. For example, they are used in epidemiological investigations to assess spore prevalence in environmental samples or to study spore resistance to disinfectants. In clinical settings, they may be employed when recurrent *C. difficile* infections suggest spore persistence despite treatment. Laboratories must follow precise protocols, including pre-reducing media with agents like cysteine or resazurin, to ensure anaerobic conditions are maintained. Failure to do so can lead to false-negative results, as spores fail to germinate in the presence of oxygen.
A comparative analysis highlights the trade-offs between anaerobic cultures and alternative methods. While PCR tests offer speed and sensitivity, they cannot distinguish between viable spores and non-viable DNA remnants. Toxin assays, though quick, miss toxin-negative strains and overlook spores entirely. Anaerobic cultures, by contrast, provide definitive proof of spore viability but at the cost of time and resource intensity. For instance, a hospital laboratory might reserve anaerobic cultures for patients with treatment-refractory *C. difficile* infections, where understanding spore dynamics could inform tailored therapy.
In conclusion, anaerobic cultures occupy a niche role in *C. difficile* diagnostics, offering unparalleled insight into spore viability but demanding patience and expertise. Their time-consuming nature and specialized requirements preclude routine use, yet they remain indispensable in research and select clinical scenarios. Laboratories must weigh the benefits of spore detection against the practical constraints, opting for faster methods when timely intervention takes precedence. For those with the resources and need, anaerobic cultures provide a deeper understanding of *C. difficile*’s persistent threat.
Are Mildew Spores Dangerous? Understanding Health Risks and Prevention Tips
You may want to see also

PCR Specificity: PCR can detect *C. diff* DNA, but not differentiate between spores and vegetative cells
PCR testing for *Clostridioides difficile* (*C. diff*) is a powerful tool in clinical diagnostics, capable of detecting the bacterium's DNA with high sensitivity. However, its specificity comes with a critical limitation: it cannot distinguish between *C. diff* spores and vegetative cells. This distinction is crucial because spores are the dormant, highly resilient form of the bacterium, while vegetative cells are the active, disease-causing form. When a PCR test returns a positive result, it confirms the presence of *C. diff* DNA but leaves clinicians uncertain about whether the patient is shedding spores, vegetative cells, or both. This ambiguity complicates treatment decisions, as spores alone may not require immediate intervention unless they are germinating into vegetative cells.
To understand the implications, consider a scenario where a patient tests positive for *C. diff* DNA via PCR. Without knowing whether the detected DNA originates from spores or vegetative cells, clinicians must rely on additional clinical context, such as symptoms and toxin assays, to guide treatment. For instance, if a patient is asymptomatic but PCR-positive, the presence of spores might be less concerning than vegetative cells, which actively produce toxins. However, PCR alone cannot provide this clarity, underscoring its limitation in differentiating between these two forms. This is particularly relevant in healthcare settings, where *C. diff* spores can persist on surfaces and contribute to transmission, even in the absence of active infection.
From a technical standpoint, PCR amplifies specific DNA sequences, such as the *tcdB* gene, which encodes for *C. diff* toxins. While this approach is highly sensitive—detecting as few as 10–100 copies of the target DNA—it does not account for the biological state of the bacterium. Spores and vegetative cells share the same genetic material, making it impossible for PCR to differentiate between them. Advanced techniques, such as spore-specific PCR assays or microscopy, are required to address this gap. For example, spore-specific PCR targets genes uniquely expressed during sporulation, but these methods are not yet widely adopted in clinical practice due to complexity and cost.
In practical terms, clinicians must interpret PCR results with caution, especially in patients with recurrent *C. diff* infections. Recurrence often involves spore germination, but PCR cannot confirm this process. Instead, combining PCR with toxin detection (e.g., glutamate dehydrogenase or toxin A/B assays) can provide a more comprehensive picture. For instance, a PCR-positive, toxin-negative result might suggest the presence of spores without active toxin production, whereas a PCR-positive, toxin-positive result indicates vegetative cells causing disease. This layered approach helps tailor treatment, such as initiating antibiotics for active infection or focusing on infection control measures for spore shedding.
Ultimately, while PCR is invaluable for detecting *C. diff* DNA, its inability to differentiate between spores and vegetative cells highlights the need for complementary diagnostic tools. Clinicians should integrate PCR results with clinical symptoms, toxin assays, and patient history to make informed decisions. For example, in a nursing home outbreak, PCR might identify widespread *C. diff* DNA, but additional testing could reveal whether spores are the primary concern for environmental decontamination or if vegetative cells are driving active infections. By acknowledging PCR’s specificity limitations, healthcare providers can optimize diagnostics and treatment strategies for *C. diff* infections.
Mastering Morel Mushroom Propagation: Effective Techniques to Spread Spores
You may want to see also
Frequently asked questions
Most standard C. diff tests, such as toxin assays or PCR tests, are designed to detect the presence of toxins or the bacteria itself, not specifically the spores. However, some advanced molecular tests may indirectly indicate spore presence by detecting the bacteria, as spores are a form of C. difficile.
Detecting C. diff spores is crucial because spores are the primary means by which C. difficile spreads and persists in the environment. Even if the active bacteria or toxins are not present, spores can germinate into active bacteria, leading to infection or recurrence.
Currently, there are no widely available clinical tests specifically designed to detect C. diff spores. Research methods, such as spore culture or spore-specific molecular assays, exist but are not routinely used in clinical settings. Standard tests focus on active infection markers like toxins or bacterial DNA.

























